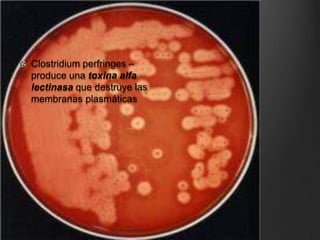
Clostridium perfringes –
produce una toxina alfa
lectinasa que destruye las
membranas plasmáticas

Las enfermedades infecciosas han constituido uno de los problemas de salud más importantes. El desarrollo de antibióticos y la quimioterapia aumentaron la esperanza de vida en 30-40 años. Existen bacteriostáticos que impiden la multiplicación bacteriana y bactericidas que destruyen bacterias. También existen quimioterápicos sintéticos y antibióticos producidos por microorganismos.